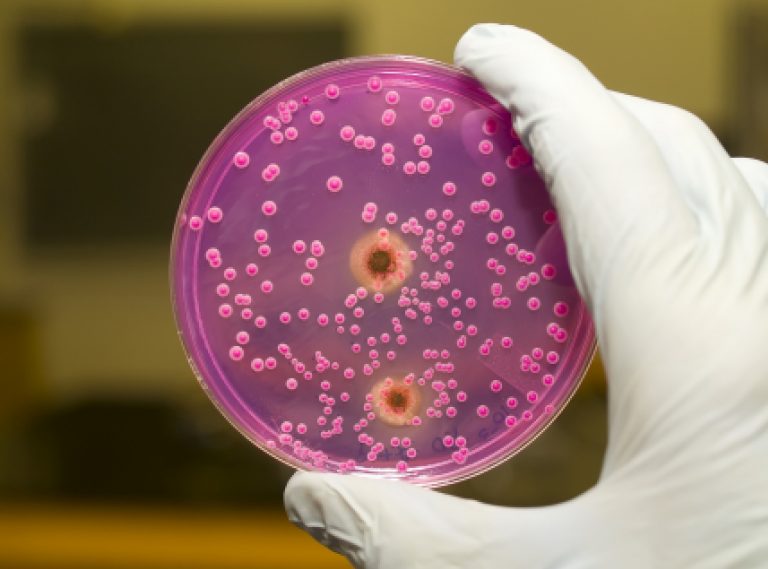

Гной В Сперме

💣 👉🏻👉🏻👉🏻 ВСЯ ИНФОРМАЦИЯ ДОСТУПНА ЗДЕСЬ ЖМИТЕ 👈🏻👈🏻👈🏻
Запишитесь на прием к венерологу по телефону +7(495) 256-49-52 или заполнив форму online
Гной в сперме в большинстве случаев обозначает такое урологическое заболевание, как пиоспермия. Она считается достаточно частой на сегодняшний день – урологи могут это подтвердить по тому количеству жалоб, которые они получают. Конечно, для точного определения заболевания и последующего назначения терапевтических процедур необходимо медицинское обследование. Но первичное наблюдение за состоянием спермы тоже дает определенные результаты.
Например, если у мужского семени отмечается зеленовато-желтая расцветка и очень неприятный запах, это может быть заметным признаком вышеуказанной болезни. Само же проведенное обследование позволяет уже обнаружить число лейкоцитов, распадающихся клеточных элементов, других микроорганизмов, от чего уже врач отталкивается при назначении подходящей терапии.
В частности, из возможных обследований необходимыми оказываются следующие:
Нередко пиоспермия может сочетаться с некоторыми другими недугами, вроде гемоспермии или тератозооспермии. Образование же гноя зачастую происходит непосредственно в органе уретры, яичных придатках, зоне предстательной железы. Выделение токсических веществ происходит микроорганизмами, повреждающими вдобавок к этому сперматозоиды.
Из-за токсинов увеличивается различное число патологий, и нарушаются показатели подвижности спермиев. Такие процессы ухудшают способность мужскому семени оплодотворять. Вместе с тем необходимо помнить о реальности излечения подобной ситуации притом, что не будет осложнений.
Как бы там ни было, само наличие пимоспермии зачастую свидетельствует о начале и последующем развитии воспалительных процессов в половой области. При обнаружении таких заболеваний понадобится урологическое обследование и, соответственно, терапевтические процедуры.
При обнаружении подобной патологии, в обязательном порядке требуется назначение компетентного лечения после проведенного специалистами обследования.
Что касается обследования, данные процедуры изначально направлены на выявление основных причин того, почему гной в сперме появился. Прежде всего, это важно, поскольку явление пиоспермии больше рассматривается в качестве признака и следствия какого-нибудь более серьезного недуга. После того, как причины выявлены, назначается лечение, направленное на снижение воспалительных процессов.
Если говорить о конкретных болезнях, признаком и следствием которых может быть появления гноя в сперме, то это может быть гнойный везикулит, а также простатит.
Отдельно следует говорить о терапевтических процедурах, назначаемых при выявлении пиоспермии. Лечение должен контролировать квалифицированный медицинский специалист, а непосредственные процедуры могут назначаться лишь тогда, когда проведено комплексное обследование и принято решение насчет того, как именно устранять существующую проблему.
Если заниматься самостоятельным лечением или довериться неквалифицированному специалисту, который поставит некорректный диагноз, могут быть значительные осложнения. Поэтому к лечению пиоспермии необходимо относиться со всей ответственностью. Кроме того, начало лечения должно быть своевременным, чтобы имеющаяся болезнь не стала хронической или еще больше не усложнилась.
Данная статья размещена исключительно в познавательных целях и не является научным материалом или профессиональным медицинским советом.
Услуги по подбору врачей предоставляются бесплатно.
Информация на сайте предназначена для ознакомления и не призывает к самостоятельному лечению. Для установления диагноза и получения рекомендаций по лечению необходима консультация квалифицированного врача.
Адрес: г. Москва. Сайт носит исключительно информационный характер и не сотрудничает с медицинскими центрами. Рекламу не продаем.
Пиоспермия – наличие воспалительного процесса в мочеполовой системе мужчины, при котором в семенной жидкости появляется гной. Семенная жидкость при этом нередко имеет серовато-зеленоватый оттенок и обладает неприятным запахом. Источниками гноя могут быть различные отделы половых органов, но преимущественно это придатки яичек, семенные пузырьки, уретра или предстательная железа. Токсины выделяются микроорганизмами и оказывают на сперматозоиды негативное воздействие, нарушая их подвижность и увеличивая количество патологических форм, что естественно, делает пиоспермию и беременность практически несовместимыми понятиями.
Нередко причинами пиоспермии становятся такие серьезные заболевания, как туберкулез яичек или предстательной железы. Зачастую пиоспермии сопутствуют такие заболевания, как олигоспермия, гемоспермия, тератозооспермия.
Причиной пиоспермии могут служить запущенные стадии уретрита, эпидидимита, орхита и других заболеваний, приводящих к тому, что сперма наполняется болезнетворными микроорганизмами и продуктами клеточного распада, выделяющими ядовитые токсины.
Независимо от причины, наличие гноя в сперме всегда свидетельствует о присутствии какого-либо урологического заболевания. Для адекватного лечения пиоспермии мужчине необходимо пройти комплексное урологическое обследование, включающее такие исследования:
Основным внешним симптомом пиоспермии является существенное ухудшение качества спермы. Семенная жидкость становится серовато-зеленого цвета и имеет неприятный, иногда довольно резкий запах. Так как данное заболевание способствует замедлению подвижности сперматозоидов, то беременность при пиоспермии представляется маловероятной.
По результатам спермограммы определяется повышенное содержание лейкоцитов. Нередко в сперме обнаруживаются патологические процессы, патогенные микроорганизмы и остатки клеточного распада.
При наличии гноя в сперме следует заподозрить у пациента следующие признаки:
Стоит отметить, что существует также ложная пиоспермия, когда гной проникает в сперму в результате ее прохождения по мочеиспускательному и семенным каналам, а не образуется непосредственно во время сперматогенеза.
Что касается лечения данного заболевания, в первую очередь оно заключается в выявлении причины. Пиоспермия – это не самостоятельная болезнь, а скорее признак, свидетельствующий о наличии воспалительного процесса в мочеполовой системе. После выявления причины можно назначать противовоспалительную терапию.
Если говорить непосредственно о процессе лечения пиоспермии, то проводиться оно должно под контролем опытного врача. Адекватное лечение возможно только после окончательного диагноза, подтвержденного комплексным обследованием. Неверно же поставленный диагноз может повлечь за собой серьезные осложнения.
Информация является обобщенной и предоставляется в ознакомительных целях. При первых признаках болезни обратитесь к врачу. Самолечение опасно для здоровья!
Наши почки способны очистить за одну минуту три литра крови.
Упав с осла, вы с большей вероятностью свернете себе шею, чем упав с лошади. Только не пытайтесь опровергнуть это утверждение.
Человеческие кости крепче бетона в четыре раза.
Люди, которые привыкли регулярно завтракать, гораздо реже страдают ожирением.
Согласно исследованиям ВОЗ ежедневный получасовой разговор по мобильному телефону увеличивает вероятность развития опухоли мозга на 40%.
Многие наркотики изначально продвигались на рынке, как лекарства. Героин, например, изначально был выведен на рынок как лекарство от детского кашля. А кокаин рекомендовался врачами в качестве анестезии и как средство повышающее выносливость.
Существуют очень любопытные медицинские синдромы, например, навязчивое заглатывание предметов. В желудке одной пациентки, страдающей от этой мании, было обнаружено 2500 инородных предметов.
Во время чихания наш организм полностью прекращает работать. Даже сердце останавливается.
Раньше считалось, что зевота обогащает организм кислородом. Однако это мнение было опровергнуто. Ученые доказали, что зевая, человек охлаждает мозг и улучшает его работоспособность.
74-летний житель Австралии Джеймс Харрисон становился донором крови около 1000 раз. У него редкая группа крови, антитела которой помогают выжить новорожденным с тяжелой формой анемии. Таким образом, австралиец спас около двух миллионов детей.
По статистике, по понедельникам риск получения травм спины увеличивается на 25%, а риск сердечного приступа – на 33%. Будьте осторожны.
В четырех дольках темного шоколада содержится порядка двухсот калорий. Так что если не хотите поправиться, лучше не есть больше двух долек в сутки.
Читать еще: Полоскания при гнойной ангине
На лекарства от аллергии только в США тратится более 500 млн долларов в год. Вы все еще верите в то, что способ окончательно победить аллергию будет найден?
Американские ученые провели опыты на мышах и пришли к выводу, что арбузный сок предотвращает развитие атеросклероза сосудов. Одна группа мышей пила обычную воду, а вторая – арбузный сок. В результате сосуды второй группы были свободны от холестериновых бляшек.
Согласно мнению многих ученых, витаминные комплексы практически бесполезны для человека.
Задача точного установления отцовства — это такая же древняя проблема, как и поиски смысла жизни. Во все времена мужчин интересовало, своих ли они растят детей.
Одним из наиболее важных показателей здоровья репродуктивной системы мужчины, является количественный и качественный состав семенной жидкости. Но нередки случаи, когда спермограмма показывает повышенное содержание лейкоцитов, микроорганизмов и распадающихся клеток в эякуляте. Присутствующие в сперме мертвые лейкоциты указывают на пиоспермию, которая является признаком серьезного воспалительного заболевания, протекающего в мужской мочеполовой системе.
Пиоспермия всегда является следствием воспалительного процесса в мочеполовой системе, который обуславливает появление в сперме примесей гноя. При этом семенная жидкость обладает крайне неприятным запахом и специфической зеленовато-желтой или серовато-зеленой окраской.
Изменение качества спермы является главным внешним симптомом пиоспермии. Источником образования гнойных примесей могут являться различные отделы половых органов – придатки яичек, уретра, семенные пузырьки, предстательная железа. Причины пиоспермии могут быть самыми разнообразными, но все их объединяет одно – выделяемые микроорганизмами токсины оказывают на качество спермы крайне негативное воздействие, увеличивая количество патологических форм и нарушая подвижность сперматозоидов, поэтому, зачастую получается так, что пиоспермия и беременность понятия совершенно несовместимые. Лечение пиоспермии проводится только под строгим контролем специалиста.
Появление гноя в сперме может спровоцировать воспалительные процессы специфического или неспецифического характера протекающие в мочеполовой системе мужчины.
Запущенная стадия уретрита, орхита, везикулита, простатита, эпидидимита и других болезней, которые приводят к образованию гноя в эякуляте – это самые распространенные причины пиоспермии. Например, при везикулите, инфекция из задней части уретры попадает через устье семявыбрасывающего протока в семенной пузырек. До появления других симптомов, хроническая пиоспермия может быть единственным симптомом заболевания.
Нередко причины пиоспермии кроются в таком серьезном заболевании, как туберкулез предстательной железы или яичек.
Такие воспалительные процессы редко проявляют себя лишь пиоспермией, и сопровождаются, как правило, дополнительными последствиями болезни – састенозоспермией, гемоспермией, олигоспермией или тератозооспермией.
Хотя пиоспермия не всегда бывает следствием заболеваний вирусной и бактериальной природы, она всегда значительно нарушает показатели спермограммы. Воспалительные и инфекционные факторы значительно повреждают качество спермы, снижая подвижность сперматозоидов и сокращая их количество и концентрацию. Также нарушаются морфологические параметры сперматозоидов, поэтому пиоспермия и беременность хотя и могут сочетаться, это крайне нежелательно, поскольку гнойные включения в сперму, особенно имеющие инфекционную или вирусную природу, могут провоцировать патологии развития плода и оказывать крайне негативное действие на течение беременности.
Кроме того, часто встречается, так называемая, ложная пиоспермия, при которой гной образуется не в процессе спермогенеза, а проникает в сперму в результате ее прохождения по мочеиспускательному или семенному каналу.
Возможность появления гнойных примесей в эякуляте можно предположить при наличии у мужчины таких симптомов:
Поскольку пиоспермия не является самостоятельным заболеванием, а всего лишь признаком воспалительного процесса, следует провести комплексное обследование. Для начала, необходимо пойти на прием к специалисту – урологу или андрологу. Вторым диагностическим этапом является спермограмма. Осмотр доктора и результаты спермограммы позволят точно установить наличие в семенной жидкости гноя, и помогут качественно оценить фертильность мужчины.
Если анализ показал, что пиоспермия все же выявлена, необходимо будет пройти дополнительное лабораторное и инструментальное обследование для установления причины нарушения функций органов и выявления источника пиоспермии.
Могут быть назначены такие методы исследования:
Воспалительные процессы в половых органах являются нередкой причиной нарушений мужской фертильности, поэтому пиоспермия и беременность вполне могут быть взаимосвязаны между собой. Зачатие при пиоспермии может происходить, но такой диагноз — это всегда риск для нормального течения беременности
Особенности лечения пиоспермии полностью зависят от установленного диагноза. Главной целью терапии является полное устранение локализованного воспалительного процесса и дальнейшее симптоматическое лечение.
Медицинская наука на месте не стоит и предлагает эффективные современные способы терапии. Лечение пиоспермии начинается с назначения медикаментозных средств – антибиотиков, иммуномодуляторов, антимикотических веществ, витаминов, препаратов растительного происхождения, улучшающих активность сперматозоидов и др. Такое средство профилактики вирусных инфекций мочеполовой системы, как озонотерапия, также часто применяется при пиоспермии, для нормализации фертильной активности мужчины.
Читать еще: Кокцидиомикоз легких, костей, кожи: пути заражения, характерные проявления, принципы лечения и профилактика
Данная статья размещена исключительно в познавательных целях и не является научным материалом или профессиональным медицинским советом.
При планировании беременности зачастую только женщины проходят обследование, в то время как мужчины уверены, что здоровы. Но мужское бесплодие тем и опасно, что проходит без симптомов. Репродуктивная функция мужчины во многом зависит от спермы. Ее количество и качество определяет шансы на успешное зачатие и развитие плода. В этой статье подробно опишем патологию под названием пиоспермия.
Для изучения спермы существует такой анализ, как спермограмма. Он позволяет определить наличие лейкоцитов в семенной жидкости. Если обнаруживается более 1 млн лейкоцитов в 1 мл спермы, можно говорить о воспалении. В таком случае врач ставит диагнозом лейкоцитоспермию. Если помимо этого в сперме присутствует гной, диагнозом будет пиоспермия.
Гной в сперме появляется из-за типичных и нетипичных воспалительных процессов. Примечательно, но такое осложнение, как пиоспермия, возникает на самых поздних стадиях воспаления, но зачастую это первый симптом заболевания, которое стало причиной.
Так как гной влияет на качество спермы, могут возникнуть трудности при зачатии ребенка. Сперматозоиды становятся менее активными, что напрямую влияет на возможность зачать здорового ребенка. Однако шансы все-таки есть и гной не делает мужчину бесплодным.
Факторов, которые провоцируют пиоспермию, много:
Признаком пиоспермии будет обнаружение в сперме погибших лейкоцитов, либо уровень живых будет в разы превышен. Такие результаты анализов говорят о наличии серьезной болезни, которая имеет воспалительный характер и локализуется в мочеполовой системе мужчины.
Главными внешними признаками пиоспермии являются цвет (серый, зеленый или желтый) и запах спермы. Для заболевания характерны и другие симптомы:
На поздней стадии воспалительного процесса могут возникать головные боли, повышаться утомляемость, температура достигнет субфебрильных значений. Иногда у мужчины диагностируют симптомы интоксикации (боль в ногах и спине, высокая температура).
Сгустки гноя в сперме и ухудшение ее качества являются единственными внешними признаками пиоспермии. Источником воспаления и, соответственно, гноя могут быть придатки яичек, уретра, предстательная железа или семенные пузырьки. Воспаление появляется в каждой области по разным причинам.
Все заболевания, вызывающие пиоспермию, объединяет лишь то, что в сперме содержатся вредоносные микроорганизмы. Они угнетают сперматозоиды, повышают риск возникновения патологий и снижают фертильность. Такие изменения только затрудняют зачатие, но не отменяют его.
Гной содержит микроорганизмы, которые снижают активность сперматозоидов, а токсины провоцируют изменения половых клеток мужчины. Эти токсины негативно влияют не только на подвижность половых клеток мужчины, но также на другие их характеристики. Гной заставляет сперматозоиды превращаться в патологические клетки. Оплодотворение измененной клеткой приведет к аномальному развитию беременности.
Именно поэтому врачи не рекомендуют пытаться зачать ребенка при активной пиоспермии. Нужно пройти грамотное обследование, найти причину и пройти курс лечения, назначенный лечащим врачом по результатам анализов.
На этот период исключаются все половые контакты. Искусственное оплодотворение также откладывается до полного выздоровления мужчины. Дело в том, что поврежденные сперматозоиды могут помешать здоровой беременности. Патологии спермы становятся причиной выкидыша или замедления развития плода.
Чтобы получить разрешение врача на искусственное оплодотворение методом ЭКО или ИКСИ, нужно вылечить пиоспермию. Перед ЭКО и ИКСИ нужно проходить дополнительное обследование и повторный анализ спермы.
Оставить проблему без внимания, значит спровоцировать бесплодие. Длительный воспалительный процесс оказывает пагубное влияние на половые органы, и вызывает массу сопутствующих проблем. Лучше вовремя обратиться к врачу, чем заниматься самолечением.
При возникновении любого симптома из списка нужно обращаться к врачу. Пиоспермия является воспалением, которое нужно своевременно лечить. Врач изучит анамнез и жалобы, проведет осмотр, а также направит на спермограмму. Этот анализ позволяет подтвердить наличие гноя в сперме.
Так как пиоспермия является осложнением другого заболеваниям, при обнаружении гноя нужно диагностировать первопричину. Для этого определяют уровень чувствительности спермы к антибиотикам, проверяют наличие ИППП, изучают мочеполовую систему при помощи УЗИ . Если пациент сомневается в результатах анализов, он может сдать их в независимой лаборатории еще раз.
Данная необходимость обусловлена с тем, что пиоспермия может быть ложной или сочетаться с другими опасными заболеваниями, связанными с изменением спермы (гемоспермия, олигоспермия).
Читать еще: Пн
Порно Игры Для Мобильника
Порно Фото Русских Знаменитостей Сериалов
Николь Шерзингер Откровенные Фото
Кай Паркер Скачать Фильмы
Ебут Жанну Фриске
Пиоспермия (гной в сперме): причины, диагностика, лечение
Гной в сперме - doctor-moskva.ru
Пиоспермия: что это такое и как вылечить гной в сперме у …
Пиоспермия, гной в сперме
Хорошее здоровье: Гной в сперме лечение
Гной в спермограмме
Десять причин появления крови в сперме, диагностика …
gozofimedu: почему появляется гной в сперме
маска из мужского семени,кто пробовал зайдите плиз
Комки в сперме | Урологический форум — онл…
Гной В Сперме